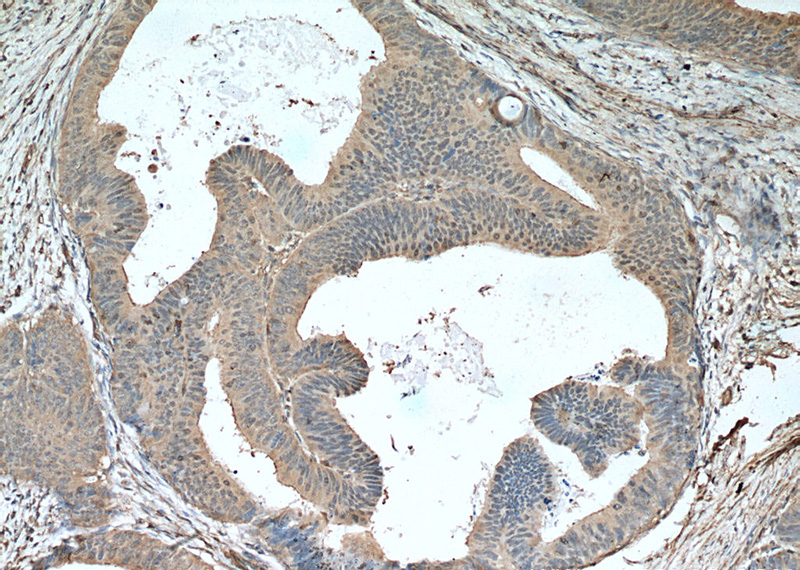
Immunohistochemistry of paraffin-embedded human colon cancer tissue slide using Catalog No:107529(Sestrin2 Antibody) at dilution of 1:200 (under 10x lens). heat mediated antigen retrieved with Tris-EDTA buffer(pH9).

-
Product Name
Sestrin2 antibody
- Documents
-
Description
Sestrin2 Mouse Monoclonal antibody. Positive WB detected in HeLa cells, L02 cells, pig liver tissue. Positive IF detected in HeLa cells. Positive IHC detected in human colon cancer tissue. Observed molecular weight by Western-blot: 54 kDa
-
Tested applications
ELISA, WB, IF, IHC
-
Species reactivity
Human; other species not tested.
-
Alternative names
DKFZp761M0212 antibody; DKFZp761M02121 antibody; HI95 antibody; SES2 antibody; SESN2 antibody; SEST2 antibody; sestrin 2 antibody; Sestrin2 antibody
-
Isotype
Mouse IgG1
-
Preparation
This antibody was obtained by immunization of Sestrin2 recombinant protein (Accession Number: NM_031459). Purification method: Protein G purified.
-
Clonality
Monoclonal
-
Formulation
PBS with 0.02% sodium azide and 50% glycerol pH 7.3.
-
Storage instructions
Store at -20℃. DO NOT ALIQUOT
-
Applications
Recommended Dilution:
WB: 1:1000-1:10000
IHC: 1:50-1:500
IF: 1:50-1:500
-
Validations

HeLa cells were subjected to SDS PAGE followed by western blot with Catalog No:107529(Sestrin2 Antibody) at dilution of 1:2000
Immunohistochemistry of paraffin-embedded human colon cancer tissue slide using Catalog No:107529(Sestrin2 Antibody) at dilution of 1:200 (under 10x lens). heat mediated antigen retrieved with Tris-EDTA buffer(pH9).

Immunohistochemistry of paraffin-embedded human colon cancer tissue slide using Catalog No:107529(Sestrin2 Antibody) at dilution of 1:200 (under 40x lens). heat mediated antigen retrieved with Tris-EDTA buffer(pH9).

Immunofluorescent analysis of (10% Formaldehyde) fixed HeLa cells using Catalog No:107529(Sestrin2 Antibody) at dilution of 1:200 and Alexa Fluor 488-congugated AffiniPure Goat Anti-Mouse IgG(H+L)
-
Background
Sestrins, including sestrin-1 (PA26), sestrin-2 (Hi95), and sestrin-3, are 48 to 65 kDa cystein sulfinyl reductases and they modulate peroxide signaling and antioxidant defense. These proteins selectively reduce or repair hyperoxidized forms of typical 2-Cys peroxiredoxins within eukaryotes. Expression of these proteins is regulated by p53, a tumor suppressor protein. Sestrin 2 is implicated in the regulation of cell growth and survival, in cellular responses to different stress conditions, and also acts as a positive regulator of autophagy. Sestrin 2 is approximately a 57.6kDa protein (480 amino acids).
Related Products / Services
Please note: All products are "FOR RESEARCH USE ONLY AND ARE NOT INTENDED FOR DIAGNOSTIC OR THERAPEUTIC USE"
